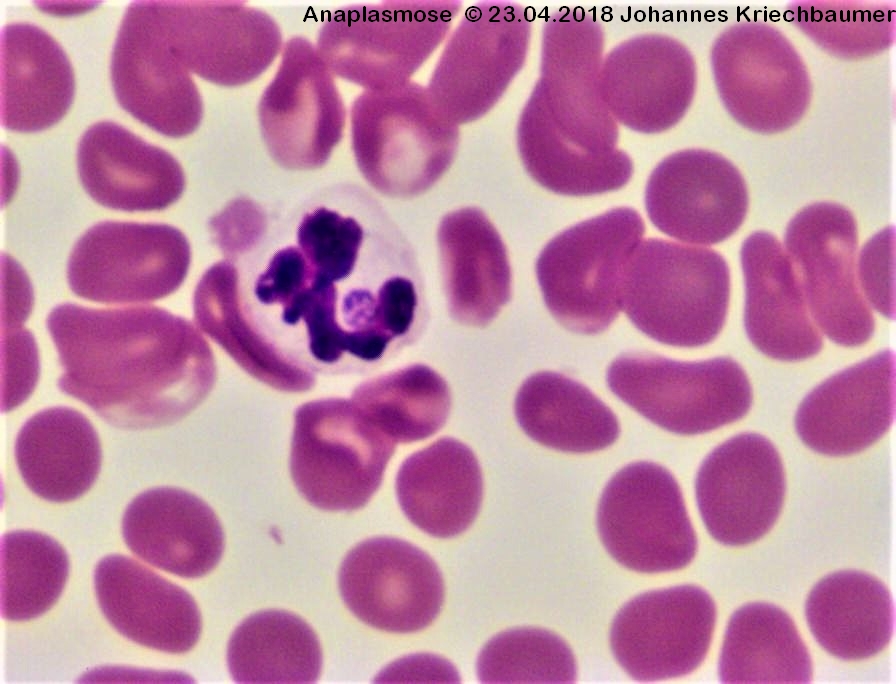

zytologie_-_anaplasmose_johannes_kriechbaumer_2018_.jpg
zytologie_-_anaplasmose_johannes_kriechbaumer_2018_.jpg
- Datum:
- 2015/04/13 19:30
- Dateiname:
- zytologie_-_anaplasmose_johannes_kriechbaumer_2018_.jpg
- Format:
- JPEG
- Größe:
- 262KB
- Breite:
- 896
- Höhe:
- 684
- Verwendung von:
- anaplasmose
Diese Liste ist möglicherweise nicht vollständig. Versteckte und durch ACL gesperrte Seiten werden nicht angezeigt.
